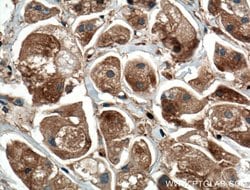
GDI1 Mouse anti-Human, Mouse, Porcine, Rat, Clone: 4E1G1, Proteintech 20

missing translation for 'onlineSavingsMsg'
Learn More
Learn More
GDI1 Mouse anti-Human, Mouse, Porcine, Rat, Clone: 4E1G1, Proteintech
Mouse Monoclonal Antibody
Brand: Proteintech 66434-1-IG-20UL
This item is not returnable.
View return policy
Description
GDP dissociation inhibitors are proteins that regulate the GDP-GTP exchange reaction of members of the rab family, small GTP-binding proteins of the ras superfamily, that are involved in vesicular trafficking of molecules between cellular organelles. GDIs slow the rate of dissociation of GDP from rab proteins and release GDP from membrane-bound rabs. GDI1 is expressed primarily in neural and sensory tissues. Mutations in GDI1 have been linked to X-linked nonspecific mental retardation.Specifications
| GDI1 | |
| Monoclonal | |
| 1 mg/mL | |
| PBS with 50% glycerol and 0.02% sodium azide; pH 7.3 | |
| P31150, P50396, P50398 | |
| GDI1 | |
| GDI1 Fusion Protein Ag17511 | |
| 20 μL | |
| Primary | |
| Rat, Mouse, Human, Pig | |
| Antibody | |
| IgG1 |
| Immunocytochemistry, Western Blot, Immunohistochemistry (Paraffin), Immunofluorescence | |
| 4E1G1 | |
| Unconjugated | |
| GDI1 | |
| GDI 1, GDI1, GDIL, GDP dissociation inhibitor 1, MRX41, MRX48, Oligophrenin 2, OPHN2, Protein XAP 4, Rab GDI alpha, RABGD1A, RABGDIA, XAP 4, XAP4 | |
| Mouse | |
| Protein G | |
| RUO | |
| 100623607, 14567, 25183, 2664 | |
| -20°C | |
| Liquid |
Product Content Correction
Your input is important to us. Please complete this form to provide feedback related to the content on this product.
Product Title
Spot an opportunity for improvement?Share a Content Correction